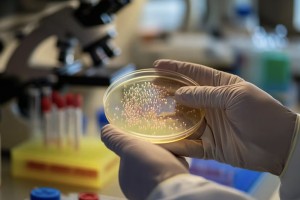

Prensa
Una técnica argentina permite cultivar piel con células del paciente: por qué puede transformar el tratamiento de quemaduras
InfobaeEl nuevo método ofrece una alternativa personalizada para reconstruir tejido cutáneo, superando los injertos tradicionales y reduciendo el riesgo de rechazo inmunológico en pacientes con lesiones severas.

La tecnología 3D se pone al servicio de los pacientes con quemaduras
CGTN NoticiasMédicos del Hospital Italiano de Buenos Aires han desarrollado una nueva versión de la máscara 3D para tratar pacientes con quemaduras graves. Asimismo, un equipo del Hospital Alemán está trabajando en otro proyecto para pacientes quemados, que también utiliza esta misma tecnología.

Aumentaron las cirugías estéticas entre los jóvenes
Nuestro díaEn épocas en las que la imagen y un determinado patrón de belleza predominan las redes sociales, las consultas para realizarse intervenciones quirúrgicas y estéticas, crecieron ¿Cuáles son las razones de estas solicitudes estéticas? ¿Es posible corresponder a las peticiones de emular a los hegemónicos filtros de Instagram?












